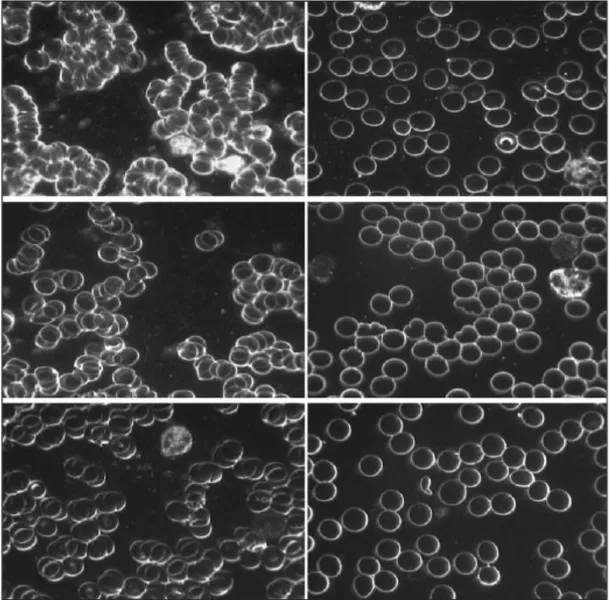

• Lưu ý rằng: Quý vị hãy chia sẻ link của bài viết, video đến người thân, bạn bè để khi độc giả thắc mắc thì We Are 1 kịp thời hỗ trợ. Không copy rồi đăng lại tránh mất các dòng tin đính kèm màu xanh (link); cũng là vi phạm bản quyền. Mời đọc kỹ “Tuyên bố bản quyền” ở cuối bài để không mất lòng nhau và hối tiếc khi chúng tôi kiện bản quyền (kể cả cá nhân và các kênh truyền thông). Xin đa tạ!
Có lẽ khi đọc tiêu đề bài viết thì quý vị đã biết We Are 1 nói về cách giải độc sóng 5G phải không? Tuy nhiên đừng vội đọc tiêu đề xong là tắt luôn hoặc chia sẻ link cho người khác. Nếu quý vị không đọc đến cuối bài sẽ không biết được cách làm như thế nào để đạt được hiệu quả nhất, rẻ tiền nhất, thậm chí là miễn phí.
Đây là một bài viết có rất nhiều tin tức về chuyên ngành và các link liên kết tham khảo, sau khi xem xong nếu muốn chia sẻ thì quý vị hãy gởi link gốc từ website weare1media.com đến người cần chia sẻ. Nếu có thắc mắc, We Are 1 chúng tôi luôn ở đây và giải đáp cho quý vị. Để có trách nhiệm với những tin tức đăng tải, chúng tôi cấm sao chép và đăng lại, nhất là những tài khoản Facebook, Ganjing lấy cớ là “vì cộng đồng”.
Mong quý vị hãy chung tay cùng We Are 1 để người Việt không bị loạn tin tức đặc biệt là trong các cách chữa bịnh, giải độc vắc-xin và những sự thật bị thế lực ngầm che giấu. Trước khi đi vào các giải pháp, mời quý vị ôn lại một chút ký ức tuổi thơ cùng chúng tôi.
Ngày còn nhỏ ở Việt Nam, đa số trẻ con dù không có điện thoại nhưng tụi nhỏ luôn biết nơi tụ tập mỗi chiều là ở đâu. Thường là một con hẻm nào đó, một góc sân hay một khoảng trống nào đó trên bãi biển. Các trò chơi thường là tạt lon, ném cù quay, thả diều, nhảy dây, đá banh…Trong các trò chơi đó nếu nhớ lại quý vị sẽ thấy có một điểm chung là đứa nào cũng đi chân đất, vì đi chân đất là chạy nhanh nhất, hay đứa nào cũng ngồi bệt dưới đất chơi trò này trò kia mà không sợ đất bẩn. Thậm chí có những khi còn lếch thếch từ dưới ruộng bắt ếch, bắt cua cũng không sợ dơ hay cũng không biết sợ vi khuẩn…
Thời đó cơ thể con người rất khoẻ phải không!? Sau dần người ta có thói quen cứ bước xuống giường là mang dép, dép đi trong nhà, dép đi ngoài đường, giữ cơ thể sạch sẽ nhưng cơ thể chúng ta càng ngày càng yếu ớt. Các phương tiện truyền thông, nhà trường đã dẫn dắt chúng ta dần dần đi theo con đường khoa học, tránh xa những nơi có vi khuẩn, virus… Thật đáng tiếc chúng ta đã bị dắt mũi từ lâu như vậy đó. Những thiện nguyện viên của We Are 1 chúng tôi cũng không thoát khỏi trong suốt những năm trước.
Sau đại dịch 2020 thì nhận thức của xã hội đã không còn như trước nữa, nên đây cũng là thời điểm hợp lý We Are 1 gởi đến quý vị những giải pháp giải độc sóng 5G – cũng là một cách giảm rất nhiều bịnh tật thời hiện đại này. Mời quý vị theo chân chúng tôi đến thăm và nghe câu chuyện của từng người sau đây, qua đó quý vị sẽ tìm thấy giải pháp hữu ích cho bản thân mình và gia đình.
Đây là một giải pháp rất mạnh mẽ nhưng cũng thật đơn giản, đơn giản tới mức người tìm ra nó – một thợ điện ở Mỹ tên là Clint Ober – đã nghi ngờ phát hiện của mình tới 20 năm…

Dưới đây là câu chuyện do ông kể lại trong một bộ phim tài liệu:
Câu chuyện của Clint Ober
Tôi lớn lên ở khu vực của người da đỏ, chủ yếu là người Cheyenne và Furrow.
Tôi còn nhớ một ngày trên đường về nhà, chúng tôi sắp bước vào lều của một đứa bé da đỏ thì mẹ của nó nói rằng: hãy cởi giày ra, nó sẽ làm con bị bịnh.
Thật lạ, bà mẹ đó nói rằng đôi giày gây ra bịnh cho tôi, lúc đó tôi không hiểu gì hết…
Cho tới đầu những năm 1960, lúc đó tôi đã lớn và đi làm; công việc chính của tôi là thợ gắn dây cáp TV. Nếu quý vị nhìn lên các cột điện sẽ thấy rằng có những dây cáp dài hàng dặm, chúng được treo trên trụ điện. Khi có sét đánh vào thì sẽ gây ra nguy hiểm cho con người phải không!?. Vì thế chúng tôi được dạy rằng cần phải nối đất dây cáp nghĩa là trước khi nối dây cáp vào một căn nhà nào đó thì nối dây xuống đất trước. Tức là cần phải tạo một đường đi xuống đất cho tia sét, để nó không đi vào nhà người ta và làm nổ TV hay gây hoả hoạn.
Có một ngày, khi tôi đang dùng máy tính, nó bị đứng nhiều lần. Với kinh nghiệm của một người thợ điện, tôi biết đây là do tĩnh điện gây ra, vì thế tôi lấy ra một cuộn băng keo kim loại ra và nối đất cho nó. Trong khi làm thì tôi nhận ra rằng ổ cắm điện chưa được nối đất, vì thế tôi đã sửa nó luôn để loại bỏ tĩnh điện, rồi cũng không nghĩ ngợi gì quá nhiều.
Sửa xong thì tôi đi ra ngoài sân và ngồi trên một cái ghế nhìn ngắm xung quanh Có một chiếc xe chở khách du lịch dừng lại, mỗi người bước xuống xe đều đi giày Nike màu trắng. Tôi đoán là họ mới từ siêu thị về và ở đó đang ở đó đang giảm giá giày Nike trắng. Khi nhìn những bước chân mang giày đi qua tôi tự hỏi rằng có phải dường như con người đã không còn được nối đất một cách tự nhiên nữa? Phải chăng những chiếc giày đó đang cản trở chúng ta?
Vì thế tối hôm đó tôi đi tới cửa hàng và mua thêm một cuộn băng keo kim loại, tôi dán nó trên giường, lấy một sợi dây điện nối qua cửa sổ, dùng một thanh kim loại cắm nó xuống đất, còn đầu kia thì nối vào băng keo kim loại trên giường. Như vậy khi nằm lên băng keo kim loại, tôi đã được nối đất, bởi vì băng keo nối dây điện với đất.

Sáng hôm sau tôi thức dậy và nghĩ: “Trời đất, có chuyện gì đó đã xảy ra. Bởi vì thông trường để ngủ được thì tôi phải dùng thuốc ngủ Advil”. Tôi cố gắng hết sức đi tìm câu trả lời. Internet vào năm 1999 thì chẳng có gì hết. Tôi đi tới đại học Arizona, vào thư viện y khoa của họ và cũng không tìm thấy gì.
Thực ra lúc đó tôi cũng đi tìm nguyên nhân của các cơn đau mãn tính, của bịnh đa xơ cứng (MS), nguyên nhân của bịnh viêm khớp… nhưng không có trong tài liệu nào hết, không ai biết cả. Vì thế tôi nghĩ, chà tôi sẽ đi tới Los Angeles, tới đại học UCLA để hỏi họ xem sao. Họ gần như đuổi tôi khỏi trường và nói: “Ông nghĩ chúng tôi sẽ tin chuyện đóng đinh xuống đất, gắn vào dây điện và nối vào ngón chân của người ta thì sẽ giúp ngủ ngon hơn? Nào hãy đi ra khỏi đây, ông bị điên rồi.”
Khi những cánh cửa đó đóng lại, tôi phải tự làm nghiên cứu cho chuyện này. Chúng tôi nối đất cho 60 người và kết quả thật đáng kinh ngạc. Rối loạn khớp thái dương hàm biến mất, hội chứng tiền kinh nguyệt biến mất, giảm viêm, giảm đau… mọi người đều ngủ ngon hơn.
Mời quý vị xem dưới đây là trường hợp của một bịnh nhân nam, ông ta đã 85 tuổi thường hay bị đau lưng và vai mãn tính, đau dữ dội. Sau 2 đêm ngủ nối đất, ông ta nói rằng vai và lưng đã giảm 50% cơn đau và 75% độ co cứng. Hình ảnh bên trái là trước điều trị, bên phải là sau điều trị.

Sau đó, một bác sĩ gây mê ở San Diego xuất hiện và nói với tôi rằng : “Tôi nghĩ đây chỉ là hiện tượng bất thường gì đó thôi. Nhưng tôi sẽ làm ông thoả mãn, tôi sẽ làm nghiên cứu để chứng minh ông sai.” Từ đó chúng tôi bắt đầu nghiên cứu.
Như đã giới thiệu tôi là một thợ điện, trước đó tôi chưa có cơ hội để làm một nghiên cứu về y học như vâỵ. sau khi hợp tác với vị bác sĩ đó tôi mới có cơ hội đầu tiên làm nghiên cứu một cách bài bản với dữ liệu rõ ràng. Tiếp sau đó chúng tôi quyết định làm nghiên cứu với quy mô lớn và rốt cuộc việc này đã thu hút các nhà khoa học, vật lý học. Khi họ nhìn thấy kết quả, mọi người đều nói “điều này thật thú vị…”
Dưới đây là ảnh chụp tình trạng viêm ở gân cẳng tay của một phụ nữ bị hội chứng ống cổ tay hai bên. Hình ảnh 1-4 cho thấy quá trình chữa lành của bà ấy bằng phương pháp nối đất:

Vậy giải thích về hiện tượng nối đất này như thế nào?
Khi quý vị dùng kính hiển vi và nhìn vào một mảnh gỗ, quý vị nhìn sâu xuống, sâu xuống hơn cả tầng phân tử, thì bỗng dưng quý vị sẽ không thấy có gì nữa, có những phân tử nhưng chúng không được kết nối với nhau. Thứ gắn chúng lại với nhau là lực hút tĩnh điện.
Cơ thể của chúng ta chạy bằng điện, các cơ quan đều là thiết bị điện: tim, phổi, não… mọi thứ đều liên quan đến điện. Những ai biết về sinh học tế bào đều đã nghe qua danh từ ATP (adenosine triphosphate) – vốn là đơn vị năng lượng của tế bào. Cơ thể chúng ta hoạt động nhờ điện sinh học. Chúng tạo ra và truyền năng lượng điện.
Ít ai biết rằng Trái Đất của chúng ta là một cục pin khổng lồ. Mặt đất tích điện âm, và tầng điện ly là một lớp khí quyển cao khoảng 96 km bị Mặt Trời làm cho ion hoá. Nghĩa là ánh sáng Mặt Trời mạnh tới nỗi nó làm cho các phân tử không khí bị phân cực thành ion âm và ion dương. Ion âm đi xuống mặt đất chủ yếu bằng tia sét, còn ion dương bay cách mặt đất khoảng 96 km.

Bịnh tật xuất hiện khi chúng ta không có đủ ion âm, vì thế chúng ta cần nối đất, cũng như chúng ta cần không khí và ánh sáng Mặt Trời.
Stephen Sinatra là một chuyên gia về bịnh tim mạch. Sau khi nghe Clint Ober kể về giải pháp nối đất, Stephen nói: “Nếu ông muốn giảm đau thì ông cần phải tìm hiểu về chứng viêm. Người ta không bị đau khớp, không bị ung thư và không có các chứng bịnh đó, mà thứ họ bị là chứng viêm mãn tính. Chúng ta bị viêm quá nhiều trong cơ thể, chúng biến thành bịnh, chúng ta đi khám bác sĩ với đủ thứ triệu chứng nhưng đa số chính là chứng viêm thầm lặng, bao gồm cả bịnh tim vốn là chuyên môn của tôi. Bệnh tim là một quá trình viêm.“
Vậy làm sao để giảm chứng viêm?
Chứng viêm do bạch cầu trung tính gây ra, chính là tế bào máu trắng. Khi có tế bào bị tổn thương, bạch cầu sẽ đến bao vây nó. Chúng giải phóng các gốc oxy hoạt tính. Các gốc này sẽ lấy electron từ tế bào bị hỏng và phá hủy nó. Nhưng nếu không có đủ electron để cân bằng, các gốc tự do còn lại sẽ tấn công cả tế bào khỏe mạnh và gây tổn thương. Khi đó hệ miễn dịch lại cử thêm bạch cầu đến. Cứ thế tạo thành một chuỗi phản ứng.
Khi chúng ta chạm vào đất qua bề mặt dẫn điện, electron sẽ từ từ đi vào cơ thể và loại bỏ các gốc tự do. Nói đơn giản, nối đất dập tắt ngọn lửa của tình trạng viêm. Viêm là nguồn gốc của nhiều bịnh như Alzheimer, ung thư, bịnh tim, tiểu đường và nhiều bịnh khác. Quý vị có nhận thấy những căn bịnh quen thuộc này không? We Are 1 đã nhắc đến chúng nhiều lần trong video “thế lực ngầm: lừa dối nhân loại qua từng bữa ăn” và video “Nỗi oan của Mặt Trời”. Nếu có thể ngăn chặn chứng viêm, tất cả chúng ta sẽ khỏe mạnh hơn.
Quý vị có thể chọn một người bị đau mãn tính, dù là bịnh gì, khi cho họ nối đất, họ đều sẽ thấy đỡ đau rõ rệt. Chứng viêm sẽ dừng lại gần như ngay lập tức. Sau đó cơ thể có thể tự phục hồi về trạng thái bình thường. Khả năng hồi phục thường tăng lên tới 60-70%.
Nếu chứng viêm là nguyên nhân gây ra nhiều rối loạn sức khỏe, thì việc không nối đất chính là nguyên nhân gây chứng viêm. Lý do rất đơn giản: khi cơ thể được nối đất thì không còn bị viêm nữa.
Nối đất làm dịu hệ thần kinh giao cảm, hỗ trợ độ biến thiên nhịp tim – yếu tố quan trọng trong cân bằng hệ thần kinh tự chủ. Nhiều người sau khi thử nối đất đã nhận thấy các lợi ích như giảm đau, ngủ ngon hơn và cảm thấy khỏe mạnh hơn.

Khoảng 70% của cơ thể chúng ta là nước. Khi nối đất, electron âm từ đất còn giúp tăng cường cấu trúc nước trong tế bào, tương tự như khi nước được tăng cấu trúc bởi điện cực âm. Tiến sĩ Gerald Pollack, tác giả cuốn “Trạng thái thứ tư của nước: ngoài thể rắn, thể lỏng và khí” ( The Fourth Phase of Water: Beyond Solid, Liquid, and Vapor) giải thích rằng “nước mang sự sống” là nước mang điện âm. Loại nước này có thể tích trữ và cung cấp năng lượng giống như pin. Về bản chất, khi nối đất, mọi tế bào trong cơ thể sẽ được nạp năng lượng để tự chữa lành.
Nối đất giúp giải độc vắc-xin
Khi chúng ta chạm vào đất qua bề mặt dẫn điện, electron sẽ từ từ đi vào cơ thể. Khi nối đất đủ lâu, electron sẽ đi vào được đến mạch máu, tại đó chúng sẽ làm loãng máu bằng cách cung cấp electron cho các tế bào hồng cầu. Nhờ đó, các tế bào đẩy lùi nhau tốt hơn, tránh bị dính vào nhau gây cục máu đông – nguyên nhân gây đau tim hoặc đột quỵ.
Nghiên cứu cho thấy electron từ đất cần khoảng 80 phút để vào máu và biến đổi các tế bào máu.
Trong cuộc sống hiện đại, khi cơ thể tiếp xúc nhiều với stress từ gốc tự do, máu sẽ có xu hướng đặc lại. Các điện tích dương tích tụ trong cơ thể gây ra chứng viêm mãn tính – nguyên nhân của hầu hết các bịnh mãn tính và thoái hóa. Nếu ta không tiếp xúc với đất, không có nguồn electron bổ sung, thì máu của chúng ta sẽ bị đặc và dễ đông cục hơn. Tình trạng viêm cũng tăng lên.
Vì vắc-xin COVID (và nhiều vắc-xin khác) gây đông máu và đột quỵ, nối đất hoàn toàn là một giải pháp có tác dụng giảm tác hại của vắc-xin.
Chúng ta có thể kiểm chứng điều này không?
Có thể. Đã có khoảng 20 nghiên cứu về nối đất được công bố trong giới y khoa. Tất cả đều đã được bình duyệt khoa học.
Mọi người biết rằng máy khử rung tim hoạt động nhờ điện để phục hồi nhịp tim. Tương tự, cơ thể cũng có thể tận dụng điện tích từ Trái Đất. Tất cả đều là năng lượng và có thể đo được.
Clint Ober từng làm một thí nghiệm: ông đứng chân trần trên đất, cầm đồng hồ đo điện cho thấy cơ thể đang được dẫn năng lượng. Bên cạnh ông là một người đi giày tennis. Đồng hồ đo cho thấy người này không dẫn năng lượng. Tuy nhiên, khi Ober chạm vào người đó, năng lượng được truyền sang và đồng hồ sáng lên.
Áp dụng trong thể thao
Tác dụng tích cực của nối đất có thể thấy rõ nhất trên cơ thể các vận động viên, vốn thường xuyên phải vận động mạnh và rất cần một giấc ngủ ngon vào ban đêm. Đội tuyển đua xe đạp Tour de France của Mỹ đã gặp Clint Ober và áp dụng nối đất từ năm 2003. Các tay đua đã ngay lập tức báo cáo phản hồi tích cực, bao gồm: giảm căng thẳng, tăng sự bình tĩnh, cải thiện khả năng ra quyết định, tinh thần và sức bền. Thậm chí nối đất còn giúp vết thương lành nhanh hơn rất nhiều so với bình thường.
Ví dụ: ảnh A bên trái là của 1 bà cụ 84 tuổi bị tiểu đường và vết thương ở cổ chân của bà đã 8 tháng không lành, sau khi được nối đất trong 1 và 2 tuần, vết thương đã lành lại (ảnh B và C). Ở bên phải là vết thương sâu của một vận động viên đua xe đạp Tour de France (ảnh A), vết thương đã lành lại nhanh chóng sau 1 và 2 ngày nối đất (ảnh B và C)

Truyền thống cởi giày của thợ mộc Bắc Âu
Bác sĩ Sinatra từng nghe bạn của mình kể về lợi ích của nối đất khi anh ta làm nghề thợ mộc ở bán đảo Scandinavi, Bắc Âu. Ở đó, nối đất là một thói quen tốt mà những người thợ luôn muốn duy trì.
“Họ đều cởi giày vào buổi sáng và đi chân trần trên cỏ ướt,” ông kể. “Anh ta đến làm việc trong vai trò một thợ mộc trẻ, và người quản lý nói với anh ta: ‘Này anh bạn, tốt nhất là anh nên cởi giày ra, vì nếu anh đến làm việc ngay bây giờ với đôi giày đó, cơ thể anh sẽ tàn tạ trong 10 năm tới. Các khớp xương của anh sẽ đau nhức. Các cơ bắp của anh sẽ đau nhức. Mọi thứ sẽ đau nhức…’
Ông bảo anh ta cởi giày ra trong một giờ vào buổi sáng. Những người thợ thường xuyên phải đập búa, khoan và đục. Những việc nặng nhọc này sẽ gây áp lực lên các mô và cơ thể. Nhưng nếu họ đặt chân xuống đất trong một giờ và nghỉ giải lao với đôi chân trần, điều đó sẽ tạo ra sự khác biệt.”
Thí nghiệm với hoa hướng dương
Tiến sĩ Gary Schwartz tại đại học Arizona đã thực hiện một thí nghiệm thú vị với hoa hướng dương để chứng minh tác động sinh học mạnh mẽ của việc nối đất.
Như hình ảnh dưới đây cho thấy, một nhóm hoa hướng dương được kết nối với một ổ cắm điện có nối đất thông qua một thanh kim loại mỏng đặt trong bình hoa, kết nối với một dây dẫn.
Nhóm thứ hai được kết nối với một ổ cắm không có nối đất. Tất cả hoa đều được hái tươi, từ cùng một khu vực, cùng thời điểm, và trong bình có nước sạch từ cùng một nguồn, không thêm bất kỳ chất gì.

Thí nghiệm được thực hiện mù, nghĩa là nhà nghiên cứu không biết ổ cắm nào có nối đất. Như quý vị có thể thấy, đến ngày thứ bảy, một nhóm hoa đã héo úa rõ rệt, trong khi nhóm còn lại vẫn tươi tắn và mọng nước. Như giả thuyết, nhóm giữ được độ tươi là nhóm được kết nối với ổ cắm có nối đất.


Điều đáng chú ý hơn là sự khác biệt đáng kể về tỷ lệ sống sót – hoa được nối đất sống thêm 10 ngày sau khi nhóm không nối đất đã héo úa và chết!
Theo Clint Ober, điều này không quá bất ngờ vì hoa mọc trong đất nhận được nguồn năng lượng liên tục từ đất. Thanh nối đất sử dụng trong thí nghiệm này hiệu quả mô phỏng kết nối tự nhiên với đất, giúp hoa phát triển lâu hơn, như thể chúng chưa bao giờ bị hái. Vậy, liệu khái niệm này có thể áp dụng để cải thiện sức khỏe con người? Có nhiều bằng chứng thuyết phục cho thấy điều này là hoàn toàn khả thi và đang xảy ra…
Giải độc sóng 5G
Nối đất còn có một lợi ích khác: vô hiệu hoá tác động của sóng điện từ lên cơ thể quý vị, bao gồm tất cả các loại sóng Wi-Fi, sóng điện thoại, sóng 5G v.v. vốn đang ngày càng tràn lan trong cuộc sống hiện đại của con người và gây ra đủ loại vấn đề.
Theo tiến sĩ Henry Ealy, chuyên gia về chữa lành tự nhiên, thì nối đất là giải pháp duy nhất có hiệu quả trước sóng 5G. Cho dù thế lực ngầm có phát sóng mạnh tới đâu thì quý vị sẽ không hề chịu ảnh hưởng nếu được nối đất đúng cách.


Tại sao phương pháp này chưa phổ biến?
Qua câu chuyện của Clint Ober, quý vị sẽ thấy: ngay cả khi quý vị có một giải pháp tốt đã được chứng minh lâm sàng, thì giới hàn lâm vẫn sẽ nghi ngờ bởi vì họ đã bị các ông lớn ngành dược đầu độc tư tưởng từ khi còn làm sinh viên. Họ tin rằng “cái gì hiện đại mới tốt”, “cái gì có thể lấy bằng phát minh mới tốt”. Vì thế họ không quan tâm lắm tới các liệu pháp tự nhiên vốn có sẵn và giá rẻ.
Hiện tại các hãng dược đang thao túng chính phủ, giới truyền thông và giới hàn lâm, một hệ thống y tế cố hữu đã được thiết lập. Họ kiếm tiền từ các phương pháp điều trị đắt đỏ. Họ muốn duy trì điều đó. Họ không muốn có thêm đối thủ cạnh tranh giá rẻ làm giảm lợi nhuận của họ. Mục tiêu của họ không phải là giúp người, mà họ chỉ muốn kiếm tiền.
Vậy nối đất như thế nào?
Quý vị có thể đi chân trần trên các bề mặt sau: cát ướt ở bãi biển, cỏ (nếu ướt sẽ tốt hơn), đất, bê tông và gạch (không sơn phủ), gạch men lót nền.

Giày đế da có thể nối đất, còn giày đế cao su thì không.
Quý vị còn có thể nối đất khi chạm vào vòi nước kim loại khi đánh răng, hoặc chạm chân vào thanh chắn kim loại trên máy bay khi đang bay.
Các bề mặt không thể nối đất bao gồm: nhựa đường, gỗ, nhựa, hắc ín hoặc các chất cách điện.
Quý vị cũng có thể mua các tấm nối đất (earthing mat) bán sẵn để trải lên ghế, giường và luôn được nối đất khi ngồi làm việc, khi nằm ngủ.

Hãy tập thói quen nối đất vào mọi lúc mọi nơi, khi đang làm việc, khi nghỉ giải lao, khi đi dạo. Tuy nhiên, lưu ý đừng nối đất nếu quý vị đang dùng thuốc làm loãng máu như Coumadin. Nó sẽ làm máu loãng nhiều hơn nữa.
Theo nghiên cứu, sau khi nối đất 80 phút thì các electron từ mặt đất sẽ thấm vào tới mạch máu và làm cải thiện máu của quý vị. Vì vậy, hãy nối đất ít nhất 80 phút mỗi ngày, nhất là khi quý vị cần giải độc vắc-xin.
Bởi vì các chứng đông máu, đột quỵ, rối loạn hệ vi sinh đường ruột, chứng tự kỷ, tổn thương thần kinh và nhiễm độc vắc-xin đều có liên quan tới nhau (chúng tôi sẽ phân tích trong bài viết khác), do đó quý vị cũng có thể thử cho nối đất đối với các trẻ em tự kỷ, cũng sẽ có thể giúp cải thiện tình trạng sức khoẻ.
Một số thiện nguyện viên của We Are 1 có một thói quen là: vào mỗi buổi sáng họ đứng trên nền đất ngoài vườn để luyện 5 bài công pháp của Pháp Luân Công. Vì thế họ có khả năng chịu áp lực công việc rất lớn khi đi tìm tin tức và những nghiên cứu về giải độc cho cộng đồng. Nếu quý vị có thể kết hợp nối đất với 5 bài khí công này thì cơ thể và tinh thần quý vị sẽ nhanh chóng đạt trạng thái tuyệt vời nhất, vui khỏe nhất. Quý vị có thể xem hướng dẫn tại video này:
(Chú ý rằng tư thế tay của nam và nữ khác nhau. Chi tiết sự khác nhau về tư thế tay, mời xem tại link này)
Lời kết
Trong suốt lịch sử, con người chủ yếu đi chân trần hoặc mang giày dép làm từ da động vật. Họ ngủ trên mặt đất hoặc trên da động vật. Thông qua tiếp xúc trực tiếp hoặc thông qua da động vật ẩm ướt do mồ hôi (vốn có tính dẫn điện), các electron tự do dồi dào từ mặt đất có thể xâm nhập vào cơ thể. Qua cơ chế này, mọi bộ phận của cơ thể có thể cân bằng với tiềm năng điện của Trái Đất, từ đó ổn định môi trường điện của tất cả các cơ quan, mô và tế bào.
“… Tôi nghĩ lý do chúng ta có một thế hệ trẻ em mắc bịnh tiểu đường là vì chúng ta đã tách trẻ em khỏi mặt đất, cho chúng ăn nhiều đường và không tập thể dục. Đó là cơn bão hoàn hảo,” – tiến sĩ Stephen Sinatra.
Lối sống hiện đại đã ngày càng tách con người khỏi dòng chảy nguyên thủy của electron Trái Đất. Kể từ thập niên 1960, chúng ta ngày càng sử dụng giày dép có đế cách điện bằng cao su hoặc nhựa, thay vì giày da truyền thống làm từ da động vật. Việc sử dụng vật liệu cách điện trong giày dép sau Chiến tranh Thế giới thứ 2 đã tách chúng ta khỏi trường năng lượng của Trái Đất. Rõ ràng, chúng ta không còn tiếp nhận dòng năng lượng mạnh mẽ từ đất mẹ như xưa kia.
Sau khi xem đến đây, quý vị có lẽ đã hiểu rằng mặt đất dưới chân chúng ta thật kỳ diệu phải không? Đó là một hệ thống đã được thiết kế để mang lại lợi ích cho con người, đó là hồng ân của Sáng Thế Chủ. Quay về với tự nhiên, với văn hoá truyền thống chính là con đường đúng đắn để giải độc vắc-xin cũng như giúp chúng ta có cuộc sống bình yên trong thời loạn lạc ngày nay.
We Are 1 luôn đồng hành cùng cộng đồng người Việt bằng những nguồn tin chính xác. Sau nhiều năm trên chiến trường truyền thông, đến nay We Are 1 đã trở thành một kênh tin tức hữu ích cho cộng đồng người Việt. Chúng tôi trân quý từng sinh mạng người Việt như trân quý hơi thở của chính mình. Chúc quý vị có những quyết định đúng đắn trước những tin tức giả dối đang được ma quỷ gieo rắc khắp nơi trên mạng xã hội.
Các tin LIÊN QUAN
💁 TUYÊN BỐ BẢN QUYỀN:
Quan điểm đưa ra trong video, bài viết của We Are 1 không có ý định xúc phạm bất kỳ tôn giáo, nhóm thiểu số, tổ chức, công ty, cá nhân hay bất kỳ ai.








